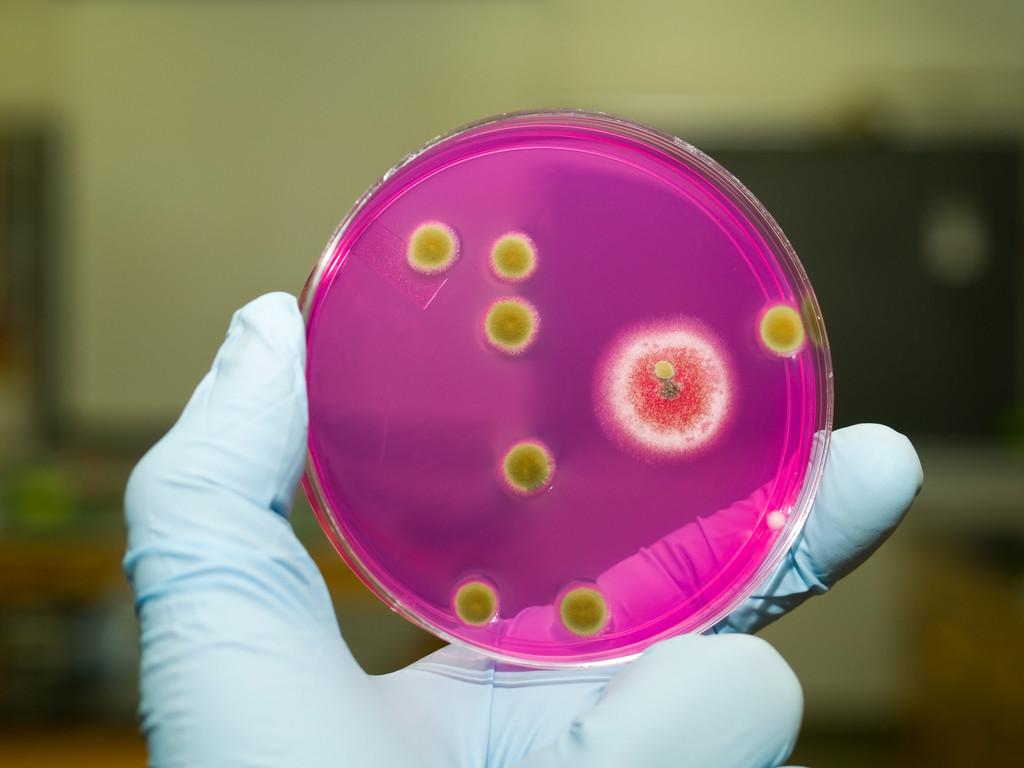
\

SCI论文(www.lunwensci.com):
摘要:高校微生物课程是生物专业必修的专业课之一,针对微生物学发展快,传统课堂教学内容滞后于微生物学发展等问题,笔者借鉴大数据时代的特点,更新高校微生物基础教学内容,优化微生物课程体系并进行改变教学方式。通过三个方面的的改革以及实际的课堂实践分析,改革后的微生物教学在课堂教学效果以及学生掌握情况得到了明显的改善,对高校微生物学以及其他专业课课改具有实际的应用意义。
关键词:高校微生物学;大数据;基础教学;改革与实践
本文引用格式:袁博,等.大数据时代高校微生物基础教学改革和实践——以江苏师范大学为例[J].教育现代化,2019,6(87):58-60.
微生物学是生物专业的基础专业课之一,也是其他相关生物专业的核心课程之一[1]。该课程具有基础性、实践性和应用等特点,同时其分支学科也较多,在应用微生物学、环境微生物、医学微生物、工业微生物、微生物工程等专业均有体现。在实际工业生产中,微生物学也扮演了重要的角色。随着大数据时代的到来,微生物也得到了快速的发展,高通量测序技术的开发与发展为微生物发展提供了重要的发展技术契机[2],基因组学、蛋白质组学、代谢组学三大组学的快速发展,为微生物的发展奠定了新的知识增长点[3]。近三年,有关微生物三大组学的文章呈指数式增长,而由此带来的微生物学新知识、新技术、新应用也成为微生物学快速发展的动力。而在实际的高校微生物学教学中,教师对知识点的传授还建立在传统的书本知识,课堂知识点更新不及时,造成学生在后期阅读相关文献时出现一定程度的理解障碍。本论文针对性的探讨了大数据下微生物学的课堂教学方式改革,通过实际的教学获得一定的经验。
一 大数据背景下微生物学发展
20世纪末,随着微生物分子生物学的发展,对微生物样品的处理、分析方法发生了快速的发展,传统的微生物鉴定方法并不能完全反映出微生物信息[4]。随着克隆文库、测序技术的发展,传统的微生物研究方法被新的技术迅速取代,也大大促进了微生物学的发展。高通量测序对环境微生物的快速发展提供了重要的技术支撑。2005年,Roche 454,Illumina Solexa测序和ABI solid测序技术在内的第二代测序技术开启了微生物学的大数据时代[5]。大数据本身的特点在于在一定的时间范围内,使用常规的统计软件进行数据的获得、管理和分析,获得一定的数据集合后,通过统计算法得到一定的具有规律性的结果,对解决问题具有重要的指导意义。目前,大数据时代的典型特征是:体量大、类型多、价值密度低、处理速度快,简称4V(大数据的产业应用)[6]。对于微生物来说,高通量测序技术提供了大量微生物信息以及快速的信息处理技术让研究人员可以迅速的获得环境中微生物的种群信息,并且通过相关性分析获得了不同微生物之间的关系。宏基因组(metagenomics)自提出以来,通过对环境中微生物群落的遗传物质进行研究,可以充分挖掘未培养和未鉴定的微生物基因多样性,可以帮助研究人员更深入的研究微生物相关功能,拓展了对微生物种群和功能的认知,通过近10年的发展,已经形成了成熟的微生物技术之一。代谢组学和蛋白质组学是得益于色-质谱学的快速发展形成的应用技术手段。代谢组学和蛋白质组学可以帮助研究人员了解微生物在外界生物或非生物环境改变下微生物自身代谢途径,更加有利于了解微生物的功能。因此,在以上技术的快速发展下,微生物学知识点的更新效率得到了有效的提高。
二 大数据下高校微生物教学现状
笔者通过调研,对目前大数据下高校微生物教学现状进行了总结。
(一)教学内容一成不变,教学大纲墨守陈规
在现行的高校微生物教学中,教师仍然采用传统的微生物教材进行课堂讲授,对新原理、新观点讲授较少,教学大纲也不能与时俱进,与实际的科研脱钩。
(二)教师对微生物大数据的理解不清
许多教师认为大数据只是在计算机科学中存在,忽略生物大数据本身的特点,对生物大数据分析没有清晰的概念,这样在课堂教学中会有意避开相关问题的讨论,使得学生无法正确、及时获取相关知识。
(三)不善于跟踪科研进展
生物学科本身建立在实验基础之上,而相关老师在授课时并没有对相关知识点的科研进行跟踪,有些原理和知识点已经更新,但课堂上教师仍然采用默认的知识点讲授,使得学生获取的知识点与实际情况脱钩。
(四)不善于引导学生
教师在课堂上片面追求教学进度,对于遇到新知识点或者难点时,并没有旁征博引引导学生理解,使得学生对学习逐渐失去主动学习的兴趣。
(五)重理论,轻实践
许多教师在理论课教程时过分强调基础理论的作用,忽略实验课或者科研训练时对学生进行理论联系实际的能力培养,使学生科研能力下降。
三 大数据下高效微生物教学改革
(一)教学内容的及时更新
笔者通过NCBI、谷歌学术等订阅功能,及时更新“Microbiology”,“Technology”等关键词,并对现阶段发表的微生物基础研究以及微生物研究方法进行总结,结合现行教材中相关章节的知识点在课程备课中进行合理的穿插,形成更新的知识点。同时在教学大纲中进行注释,对已经证实的微生物新研究和技术进行更换原有内容,形成完整的、时效的教学内容更新。
在讲授《微生物代谢》章节中,笔者将最新的代谢组学引入传统的微生物代谢知识点中,强化了代谢网络的知识点,优化了传统的微生物糖代谢在代谢中的重要性,强调糖代谢在整个代谢网络中的重要性,通过引入代谢流这一新的理论点让学生加深了碳循环在整个微生物代谢中的重要基础作用。
实验教材内容主要是培养学生的创新精神和应用能力。结合大数据时代下,微生物测序技术、组学技术的技术特点,在更新微生物实验内容方面,需要整理和编写内容丰富、创新、结构信息完整、具备多种形式的微生物实验教材,同时引进相关新技术的特点,将这些新技术与现行微生物实验中相关的技术进行类比,对新技术的优缺点进行总结,构建与理论教学内容相统一以及相辅相成的实验教学体系和内容,完成对微生物学实验教学内容的更新。
在进行《微生物培养》实验课程备课中,笔者充分考虑了使用测序技术对不可培养微生物的鉴定这一功能,引入构建克隆文库技术的知识点,更新了微生物鉴定实验的内容,让学生对高通量测序技术有了更深一步的认识。
(二)优化课程体系
大数据时代的另一个典型特征是计算机学科的交叉引入。对于微生物学,计算机并不仅仅是简单的数据处理载体,还包括数据存储、传输以及潜在信息分析等方面功能,因此在优化微生物课程方面需要引入计算机学科的发展现状,及时优化微生物课程体系。笔者在阅读相关微生物学信息学文献后,在微生物学知识体系中引入计算机相关专业知识,重点体现在优化了微生物数据处理方面的课程,通过引入各种数据模式,如R、Python等计算机语言在分析微生物大样本以及数据挖掘方面的应用,使得教学内容更加合理,使得学生在学习微生物基础知识的同时,了解相关的数据处理手段。
(三)改变教学方式
在传统的高校教学模式上,教师讲授是重要的课堂表现形式,在讲授时的现代教育技术手段也主要使用PPT、动画、视频等多媒体教学模式,学生在课堂上的相对注意力集中时间较短,无法对知识进行吸收、加工。笔者在借鉴研究生课程教法以及国外本科教学特点,采用“老师讲授+个人见解”的模式,在课程开始前的一周布置相关课程内容,并指定2-3人为一研究小组,根据提供的关键词进行查阅相关文献,并形成一个5分钟左右的文献综述报告。在每节课的最后10分钟,先由学生以“汇报”的形式在课堂上进行表现,而后教师进行总结、评价,并对其中存在的问题进行指出和解答。教师在讲授时,充分结合自身的研究情况以及最新的科研进行向学生进行知识点的传授,并适当结合网络形式向学生展示微生物新的研究技术情况。
实验教学中,对于可以开展的新技术,适当以小组的形式进行开展,例如在微生物代谢组技术实验教学中,组织学生参观高分辨质谱测试过程,并组织学生亲自动手进行微生物代谢物的提取以及前处理,加深学生对技术的印象。
与此同时,笔者加强课后与学生之间的交流,通过建立微信公众号等形式进行有针对性的课后知识点梳理,提高学生课后知识点的掌握。
(四)注重理论联系实际,培养学生综合科研素质
实际的科研训练可以帮助学生更好的理解相关原理,掌握相关技术。笔者在带学生进行科研训练,如毕业论文、创新项目时,注重培养学生运用理论知识与实际科研情况相挂钩,引导学生从实验中对课堂知识点进行验证。出现疑问时,启发学生通过查阅文献的方式进行解决。
四大数据下的微生物教学实践分析
为了验证上述改革在提高学生微生物理论知识和实验的有效性,笔者进行了实践分析。将改革后的微生物教学应用于实际教学,并对学生学习的情况进行了分析。主要分析学生在改革前后的学习的有效性以及在毕业论文综述撰写的科学性进行分析,对比结果如图1所示。
通过图1可以看出,通过教学改革,学生对微生物学的学习热情比改革之前提高了29%,拥有创新思考比改革之前提高了42.7%,在实际操作中,学生操作能力提高了45%,并且在毕业论文综述写作能力方面提高了68%。
综上所述,改革后的大数据微生物教学方法能够提高学生学习微生物学的能力,提高了微生物学教学的教学效率,具有重要的实际应用意义。
五 结束语
通过以上教学形式的改革和应用,微生物学对学生更具有吸引力,提高了学生对未知微生物的探索和学习,增加主动关注大数据时代下微生物发展的关注度,调动了学生对微生物新理论和新技术的积极性,更加有利于高效微生物学学科的发展。在后续教改中,我们仍将会以此为基础,创新教学方法,目的是为了让微生物学课程教学更具现代化、合理化、多元化以及高效化,为高校生物学科发展提供有利依据。
参考文献:
[1]王颖.浅谈制药工程专业微生物学的教学改革[J].科技致富向导,2011(29):81-81.
[2]郑磊,熊铁,王前.新一代高通量测序技术——检验医学发展的挑战与机遇[J].分子诊断与治疗杂志,2011,03(6):361-367.
[3]孔德康,王红旗,许洁,等.基因组学、蛋白质组学和代谢组学在微生物降解PAhs中的应用[J].生物技术通报,2017,33(10):46-51.
[4]燕艳,陈健,燕昌江,等.利用分子生物学技术鉴定土壤微生物的方法[J].东北农业大学学报,2008,39(3):129-133.
[5]徐疏梅.新一代DNA测序技术的应用与研究进展[J].徐州工程学院学报:自然科学版,2018,33(4):60-64.
[6]赵蓉英,魏绪秋.聚识成智:大数据环境下的知识管理框架模型[J].情报理论与实践,2017,40(9):20-23.
关注SCI论文创作发表,寻求SCI论文修改润色、SCI论文代发表等服务支撑,请锁定SCI论文网! 文章出自SCI论文网转载请注明出处:https://www.lunwensci.com/jiaoyulunwen/30206.html